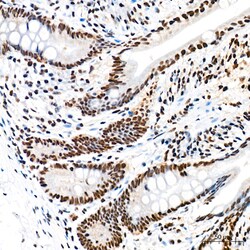
Invitrogen EFTUD2 Recombinant Rabbit Monoclonal Antibody (2Z1K3) 100 &mu;L;

missing translation for 'onlineSavingsMsg'
Learn More
Learn More
Invitrogen™ EFTUD2 Recombinant Rabbit Monoclonal Antibody (2Z1K3)


Rabbit Recombinant Monoclonal Antibody
Brand: Invitrogen™ MA557936
Les retours ne sont pas autorisés pour ce produit.
Afficher la politique du retour.
Description
Immunogen sequence: MDTDLYDEFG NYIGPELDSD EDDDELGRET KDLDEMDDDD DDDDVGDHDD DHPGMEVVLH EDKKYYPTAE EVYGPEVETI VQEEDTQPLT EPIIKPVKTK KFTLMEQTLP VTVYEMDFLA DLMDNSELIR NVTLCGHLHH GKTCFVDCLI EQTHPEIRKR YDQDLCYTDI LFTEQERGVG IKSTPVTVVL PDTKGKSYLF NIMDT.
EFTUD2 is component of the U5 snRNP complex required for pre-mRNA splicing.
Spécification
| EFTUD2 | |
| Recombinant Monoclonal | |
| 2.51 mg/mL | |
| PBS with 0.05% BSA, 50% glycerol and 0.05% ProClin 300; pH 7.3 | |
| O08810, Q15029 | |
| EFTUD2 | |
| Recombinant fusion protein containing a sequence corresponding to amino acids 1-205 of human EFTUD2 (NP_004238.3). | |
| 100 μL | |
| Primary | |
| Human, Mouse, Rat | |
| Antibody | |
| IgG |
| ELISA, Immunohistochemistry (Paraffin), Immunoprecipitation, Western Blot, Immunocytochemistry | |
| 2Z1K3 | |
| Unconjugated | |
| EFTUD2 | |
| 116 kDa U5 small nuclear ribonucleoprotein component; 116kDa; Eftud2; elongation factor Tu GTP binding domain containing 2; elongation factor Tu GTP-binding domain-containing protein 2; hSNU114; KIAA0031; MFDGA; MFDM; SNRNP116; Snrp116; Snu114; SNU114 homolog; U5 small nuclear ribonucleoprotein 116 kDa; U5 snRNP-specific protein, 116 kDa; U5-116 kDa; U5-116KD | |
| Rabbit | |
| Protein A | |
| RUO | |
| 20624, 287739, 9343 | |
| -20°C, Avoid Freeze/Thaw Cycles | |
| Liquid |
Correction du contenu d'un produit
Veuillez fournir vos retours sur le contenu du produit en remplissant le formulaire ci-dessous.
Nom du produit
Vous avez repéré une opportunité d'amélioration ?Partager une correction de contenu